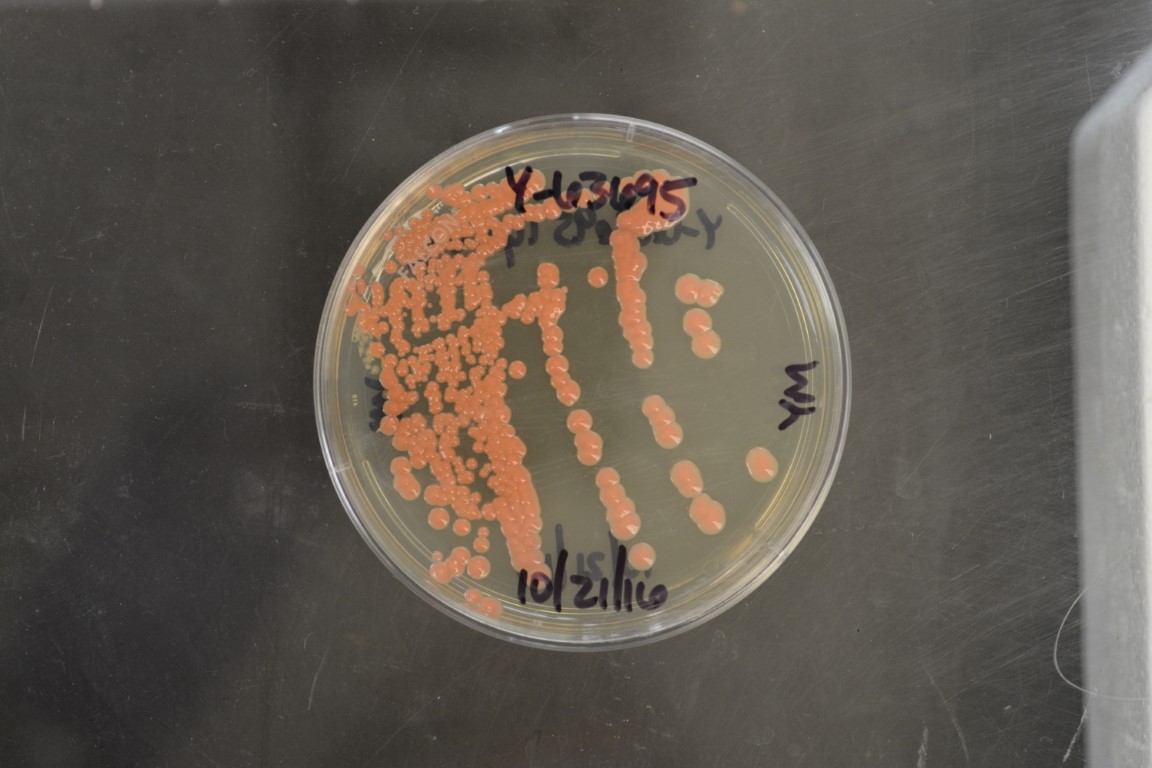

Occultifur kilbournensis
NRRL Y-63695(Type Strain)
Accession numbers in other collections:CBS 13982=NBRC 112835
Source:Cletus P.Kurtzman,NCAUR-->D.T.Wicklow
Isolated from(substrate):SL,soil from cornfield
Substrate location:Hodgkins Farm,County Road,Kilbourne,Illinois,USA
Genetic info:ID by Robnett,14 diff.D1/D2 with Occultifur externus,0 diff.D1/D2 with Y-63696,Y-63697,and Y-63698.GenBank:D1/D2(KP413160).
Growth media:Yeast Extract-Malt Extract-Peptone-Glucose(YM for yeasts)(number 6)
Optimum growth temperature:25C
Strain images:
NRRL_Y-63695_6.JPG

Comments:Growth is pink.